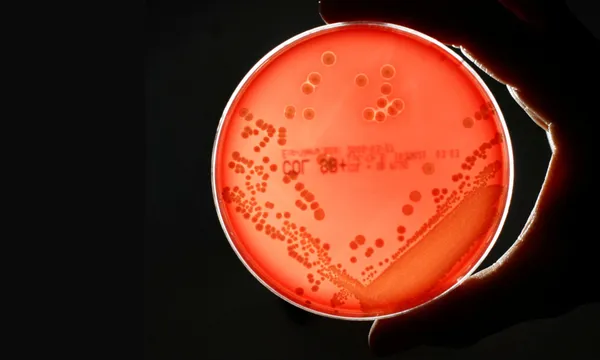

Một nghiên cứu do chính phủ Anh tài trợ cho thấy, nếu không có hành động phối hợp, tỷ lệ kháng thuốc kháng sinh (AMR) tăng cao có thể dẫn đến thiệt hại GDP toàn cầu hàng năm là 1,7 nghìn tỷ đô la.
Nghiên cứu của Trung tâm Phát triển Toàn cầu cho thấy, nền kinh tế Mỹ, Anh và EU sẽ là những nền kinh tế bị ảnh hưởng nặng nề nhất.
Ngày 17/7, chính phủ Anh thông báo sẽ cắt giảm ngân sách cho Quỹ Fleming, một quỹ chống kháng thuốc kháng sinh ở các nước thu nhập thấp và trung bình, như một phần của kế hoạch cắt giảm viện trợ rộng lớn hơn.
Chính quyền tổng thống Mỹ Donald Trump cũng xác nhận cắt giảm 9 tỷ đô la ngân sách viện trợ nước ngoài, trong khi một số nước châu Âu cũng đã giảm chi tiêu cho viện trợ nước ngoài.
Anthony McDonnell, tác giả chính của nghiên cứu, đồng thời là nghiên cứu viên chính sách tại Trung tâm Phát triển Toàn cầu đánh giá: “Việc Mỹ đột ngột cắt giảm khoảng 80% viện trợ Phát triển Chính thức; Vương quốc Anh, công bố cắt giảm viện trợ từ 0,5% xuống 0,3% tổng thu nhập quốc dân; và việc cắt giảm của Pháp, Đức và các nước khác, có thể làm tăng tỷ lệ kháng thuốc kháng sinh - theo kịch bản bi quan nhất trong nghiên cứu của chúng tôi”.
Nếu các chương trình kháng thuốc không được bảo vệ khỏi việc cắt giảm viện trợ, tỷ lệ kháng thuốc trên toàn thế giới có thể sẽ tăng với tốc độ tương đương với các quốc gia bị ảnh hưởng nặng nề nhất.
Điều này khiến hàng triệu người trên toàn thế giới tử vong, bao gồm cả các quốc gia G7. “Hiện nay, đầu tư ngay vào điều trị nhiễm trùng do vi khuẩn sẽ cứu sống nhiều người và mang lại hàng tỷ đô la lợi nhuận kinh tế lâu dài” – các nhà nghiên cứu cho biết.
Nghiên cứu đã tính toán gánh nặng kinh tế và sức khỏe do tình trạng kháng kháng sinh gây ra cho 122 quốc gia và dự báo rằng, trong kịch bản bi quan nhất này, đến năm 2050, thiệt hại về GDP ở Trung Quốc có thể lên tới gần 722 tỷ đô la một năm, Mỹ là 295,7 tỷ đô la, EU là 187 tỷ đô la, Nhật Bản là 65,7 tỷ đô la và Vương quốc Anh là 58,6 tỷ đô la.
Theo Viện Đánh giá và Đo lường Sức khỏe (IHME), số ca tử vong do AMR dự kiến sẽ tăng 60% vào năm 2050, trong đó riêng tại Mỹ có 1,34 triệu người và riêng tại Vương quốc Anh có 184.000 người được dự đoán sẽ tử vong mỗi năm do vi khuẩn kháng thuốc. Số người mắc bệnh nặng do vi khuẩn kháng thuốc cũng sẽ tăng vọt.
Siêu vi khuẩn làm tăng số lượng ca nhập viện và dẫn đến thời gian nằm viện dài hơn, phải điều trị tích cực hơn, chi phí điều trị cao hơn và việc chăm sóc phức tạp hơn, nghĩa là chi phí điều trị các bệnh nhiễm trùng kháng thuốc cao gấp đôi so với các bệnh mà thuốc kháng sinh có hiệu quả.
Nghiên cứu ước tính, chi phí y tế toàn cầu để điều trị AMR có thể tăng thêm gần 176 tỷ đô la một năm, trong khi ở Anh, chi phí này sẽ tăng từ 900 triệu đô la lên 3,7 tỷ đô la và ở Mỹ từ 15,5 tỷ đô la lên gần 57 tỷ đô la.
Nghiên cứu cũng cho thấy, tỷ lệ vi khuẩn kháng thuốc cao hơn cũng sẽ khiến lực lượng lao động ở Anh, EU và Mỹ giảm lần lượt 0,8%, 0,6% và 0,4%.
Nhưng nếu các quốc gia đầu tư nhiều hơn vào việc giải quyết siêu vi khuẩn - tăng khả năng tiếp cận thuốc kháng sinh mới và phương pháp điều trị chất lượng cao cho các bệnh nhiễm trùng này - thì nền kinh tế Mỹ sẽ tăng trưởng 156,2 tỷ đô la mỗi năm và nền kinh tế Vương quốc Anh sẽ tăng trưởng 12 tỷ đô la vào năm 2050.



